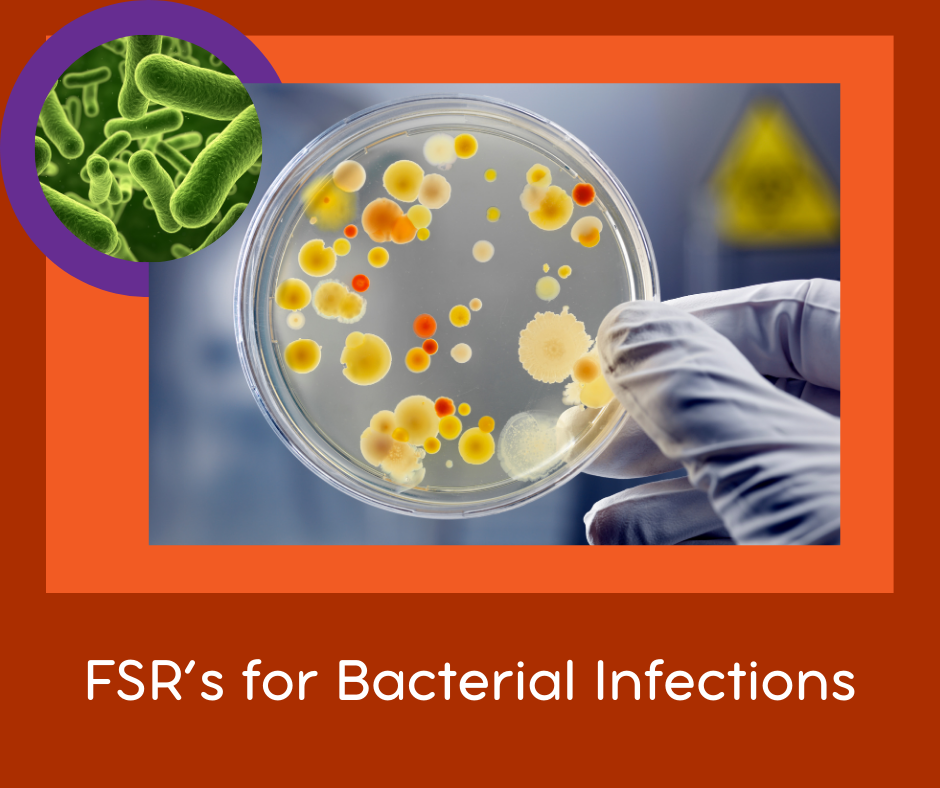

FSR set B: General Bacterial Infections:- 5x FSRs
FSR's are sound files that, when played on your body, influence the vibration of your body. The result of this is that your system can have a positive change in response to the sound.
This is the Resonance Treatment contains the FSR for general Bacterial Infections.
There are 5 files each 3 min long that you need to play in a playlist - perhaps together with your specific bacteria FSR (like Strep Viridans or Klebsiella or which ever you were diagnosed with).
Bacteremia is bacteria in your bloodstream. Without treatment, bacteremia can progress to sepsis. Sepsis is when your immune system overreacts to the infection and attacks normal tissues and organs.
You may also need to add natural antibacterial herbs and supplements like garlic, oregano oil, tea tree oil or the like.
The FRS's in this set:
- Bacterial Infections Gen P-SMS 3 min.ogg (1.3 mb)
- Bacteremia H-SMS 3min.ogg (1.9 mb)
- Bacteremia H-SMH 3min.ogg (3.1 mb)
- Bacterial Capsules Broad Spectrum #1 GB SMS 1 min.ogg (551 kb)
- Bacterial Capsules P-SMS 3 min.ogg (739 kb)

